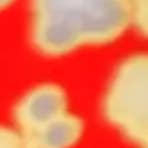

Produits similaires
Produits similaires

Best-seller
Boucles d'oreilles petites BOTO / 2 couleurs en vente B2B
Prix revendeur
PVC : 25,00 €
Couleur
Vert
Livraison et politiques
- Date de livraison estimée : 8‑20 janv.
Retours gratuits et faciles. En savoir plus
Achetez des produits B2B uniques pour votre magasin sur Faire auprès de marques telles que Elmer et bien plus encore.
Description
🌸✨ Les boucles BOTO, en acier inoxydable, aiment attirer les regards sans jamais trop en faire. Leur secret ? Une pampille recouverte de papier washi japonais – délicat mais solide – protégée par une résine brillante, avec au dos des émaux assortis (parce que l’arrière mérite aussi de briller). La pièce centrale, en demi-cercle, s’orne d’une petite pampille dorée, lisse et elle aussi en forme de demi-cercle, histoire de jouer la carte de l’élégance jusque dans les détails. Disponibles en 4 coloris, elles s’adaptent à tous les styles et s’accordent parfaitement avec le collier court BOTO, pour former une parure raffinée et harmonieuse. Présentées sur une cartonnette et dans leur pochon en organza, accompagnée au dos de quelques petits conseils malins pour garder toute sa brillance (car oui, même les bijoux aiment qu’on prenne soin d’eux 😏). Et comme elles sont faites main, chaque paire garde son petit grain d’originalité… pile ce qui les rend uniques 💫.
Détails
Pays de fabrication : France Matériau : Acier inoxydable, Papier, Résine et Émail Set : Individuel Style : D'inspiration culturelle et Tendance Thème : Nature Langue du produit : Anglais, Espagnol et Français Dimensions : 3,5 x 1,8 cm (1,4 x 0,7 in) UGS : BOBOTOGV Matériaux du produit : Sans plastique Emballage : Recyclable et Recyclé